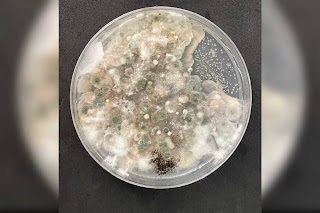

La biodiversidad microbiana del suelo: clave para la sostenibilidad agrícola
Mariela González, investigadora postdoctoral ICA3 analizó la relevancia de estos microorganismos.En el marco del Día Internacional de la Diversidad Biológica, se vuelve urgente visibilizar la importancia de los microorganismos del suelo, un componente esencial, pero poco valorado de los ecosistemas terrestres.
Estos organismos cumplen funciones clave en la salud ambiental, la productividad agrícola y la resiliencia frente al cambio climático.
investigadora postdoctoral Mariela González, del Instituto de Ciencias Agroalimentarias, Animales y Ambientales (ICA3) de la Universidad de O’Higgins, enfatiza el valor estratégico de esta biodiversidad. “La biodiversidad microbiana del suelo es fundamental para conservar el funcionamiento de los ecosistemas. Los microorganismos participan en procesos esenciales como la nutrición, la formación del suelo y el control de enfermedades, permitiéndonos aprovechar mejor los recursos naturales”.
Desde su trabajo en el Centro UOH de Biología de Sistemas para la Sanidad Vegetal (BioSaV), la Dra. González ha participado en investigaciones que muestran cómo ciertas comunidades microbianas asociadas al cultivo de tomate pueden proteger a las plantas sin necesidad de aplicar químicos.
De acuerdo a la doctora, los suelos albergan una gran variedad de microorganismos -bacterias, hongos, protozoos, entre otros- que interactúan entre sí, con las raíces y el entorno. Existen microorganismos benéficos, como algunas rizobacterias que promueven el crecimiento vegetal, hongos micorrízicos que mejoran la absorción de nutrientes, y las actinobacterias encargadas de degradar materia orgánica y generar compuestos antimicrobianos. Estos microorganismos tienen potenciales usos para una agricultura sustentable.
“Entender esta biodiversidad no es solo algo ‘bonito’ desde lo ecológico; tiene aplicaciones concretas para la restauración de suelos, reducción en el uso de métodos de control químico, y avanzar hacia sistemas agrícolas sostenibles”, afirma la investigadora.
González también destaca el rol de la investigación y la educación: “Sabemos que ciertas prácticas agrícolas pueden romper el equilibrio microbiano del suelo, afectando la salud vegetal y la productividad a largo plazo. La educación es clave para transmitir esta información a quienes trabajan directamente con el suelo. Necesitamos que se entienda como un ecosistema vivo, cuyo cuidado es indispensable”.
La biodiversidad microbiana del suelo cumple funciones esenciales para el equilibrio de los ecosistemas agrícolas, como la mejora en la absorción de nutrientes, la protección contra enfermedades y la regeneración de suelos degradados.

COMENTA ESTA NOTICIA